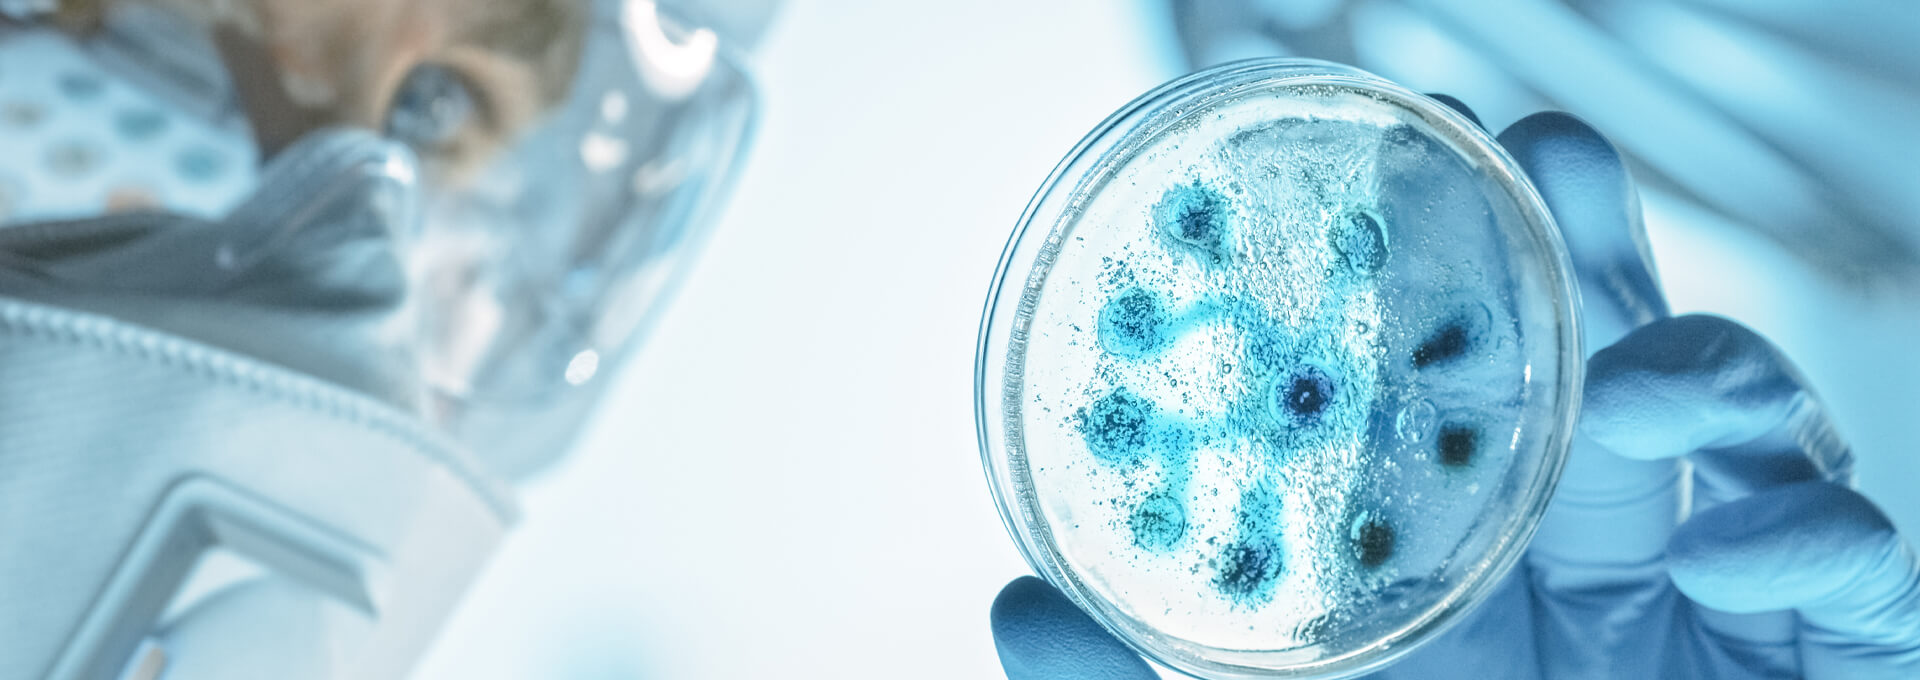
Microbiological Readiness During Sterile Drug Development

Upcoming Conferences
The Americas
Europe
Asia-Pacific













.jpg?sfvrsn=3d4085a_4)








PDA Universe of Pre-Filled Syringes and Injection Devices Conference 2026
06 - 07 Oct 2026
Palm Springs, California




PDA Miniverse: Medical Devices, Combination Products and Connected Health Conference 2026
21 - 22 May 2026
Dublin, Ireland






PDA Artificial Intelligence-A Revolution in Pharma Manufacturing Workshop 2026
11 - 12 Nov 2026
Berlin, Germany

.jpg?sfvrsn=3d4085a_4)






Upcoming Training Courses
The Americas
Europe
Asia-Pacific
Online
Fundamentals of Automated Visual Inspection Training Course (PDA 593)
27 - 28 Apr 2026
College Station, TX
Fundamentals of Aseptic Processing Training Course (PDA 800)
29 Apr - 01 May 2026
College Station, TX
Practical Application of Quality Risk Assessment Tools Training Course (PDA 531)
29 Apr - 01 May 2026
College Station, TX
Environmental Monitoring Training Certificate Program (PDA 102)
12 - 14 May 2026
College Station, TX
Aseptic Gowning Practices for Pharmaceutical Manufacturing Training Course (PDA 395)
12 - 13 May 2026
College Station, TX
Extractables/Leachables for Parenteral Applications Training Course (PDA 577)
14 - 15 May 2026
Bethesda, MD
GxP Auditing Logistics and Inspection Readiness Training Course (Including Mock Activity) (PDA 298)
19 - 20 May 2026
Bethesda, MD
Risk-Based Approach to Airflow Visualization Training Course (PDA 802)
02 - 04 Jun 2026
Bethesda, MD
Quality Management Systems for Pharmaceutical Manufacturing Training Course (PDA 813)
02 - 03 Jun 2026
Bethesda, MD
Design, Validation, and Operation of Isolator Systems Training Course (PDA 557)
24 - 25 Jun 2026
Bethesda, MD
Validation of Moist Heat Sterilization Processes Training Course (PDA 468.1)
24 - 25 Jun 2026
Online
Design, Operation, and Qualification of Pharmaceutical Water Systems Training Course (PDA 399.1)
15 - 17 Jul 2026
Online
Validation of Moist Heat Sterilization Processes Training Course (PDA 468.1)
05 - 06 Aug 2026
Online
Filtration Processes in the Pharmaceutical and Biopharmaceutical Industry Training Course (PDA 514)
17 - 20 Aug 2026
Bethesda, MD
Fundamentals of Aseptic Processing for ATMPs Training Course (PDA 294)
25 - 26 Aug 2026
Carlsbad, CA
Fundamentals of Life Sciences: Cleanrooms and Controlled Environments Production Training Course (PDA 617)
17 - 18 Sep 2026
Bethesda, MD
Foreign Particulate Examination, Isolation and Analysis Training Course (PDA 120)
01 - 02 Oct 2026
Bethesda, MD
Performing Microbial Data Deviation Investigations in the Pharmaceutical Industry Training Course (PDA 620)
01 - 02 Oct 2026
College Station, TX
Exploring Container Closure Integrity (CCI) Testing Methods Training Course (PDA 109)
07 - 08 Oct 2026
Bethesda, MD
Quality Management Systems for Pharmaceutical Manufacturing Training Course (PDA 813)
22 - 23 Oct 2026
Bethesda, MD
Identification and Classification of Nonconformities in Glass Containers Training Course (PDA 283)
26 Oct 2026
Bethesda, MD
Aseptic Gowning Practices for Pharmaceutical Manufacturing Training Course (PDA 395)
12 - 13 Nov 2026
Bethesda, MD
GxP Auditing Logistics and Inspection Readiness Training Course (Including Mock Activity) (PDA 298)
16 - 17 Nov 2026
Bethesda, MD
Fundamentals of Aseptic Processing for ATMPs Training Course (PDA 294)
18 - 19 Nov 2026
Bethesda, MD
Risk-Based Approach to Airflow Visualization Training Course (PDA 802)
18 - 20 Nov 2026
Bethesda, MD
Practical Application of Quality Risk Assessment Tools Training Course (PDA 531)
02 - 04 Dec 2026
Bethesda, MD
PDA All About Pre-Filled Syringe Systems - Basic Training Course Spring Edition 2026
16 - 17 Apr 2026
Munich, Germany
PDA Extractables and Leachables Training Course Spring Edition 2026
16 - 17 Apr 2026
Munich, Germany
PDA Container Closure Integrity Testing - Basic Training Course Spring Edition 2026
16 - 17 Apr 2026
Munich, Germany
PDA Managing Technology Transfer Projects in Pharma Training Course
28 - 29 Apr 2026
Berlin, Germany
PDA Mastering Automated Visual Inspection Training Course Spring Edition 2026
21 - 22 May 2026
Dublin, Ireland
PDA An Introduction to Visual Inspection: A Hands-On Training Course Spring Edition 2026
21 - 22 May 2026
Dublin, Ireland
PDA Fundamentals of Contamination Control for Aseptic Processing Operations Training Course
02 - 03 Jun 2026
Berlin, Germany
PDA Test Methods for Pre-Filled Syringe Systems Training Course
02 - 03 Jul 2026
Piombino Dese, Italy
Validation of Moist Heat Sterilization Processes Training Course (PDA 468.1)
24 - 25 Jun 2026
Online
Design, Operation, and Qualification of Pharmaceutical Water Systems Training Course (PDA 399.1)
15 - 17 Jul 2026
Online
Validation of Moist Heat Sterilization Processes Training Course (PDA 468.1)
05 - 06 Aug 2026
Online
Join PDA Today
Become part of a vibrant professional community. Enjoy access to valuable tools, events, and support that help you grow and succeed in your field.
Become a MemberMake an Impact
Join the leaders driving change in pharma. From expert panels to editorial boards, PDA gives you the platform to make your mark and move the industry forward.
Get InvolvedJoin the Conversation
PDA Interest Groups connect you with peers and experts to share insights, tackle challenges, and help shape the future of pharmaceutical manufacturing.
Explore Interest Groups